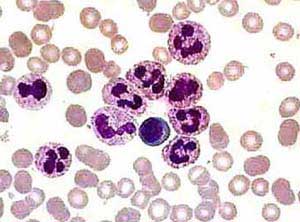
нейтрофилы

Что такое нейтрофилы
Нейтрофилы представляют собой один из типов лейкоцитов, играющих ключевую роль в защите организма от вредных микроорганизмов, а также грибковых и бактериальных инфекций. Эти клетки первыми реагируют на агрессивные агенты, вызывающие воспалительные процессы, и активно противостоят их воздействию.
Кроме того, нейтрофилы выполняют функцию своеобразных «санитаров», поглощая старые кровяные клетки и мертвые ткани, что способствует быстрому заживлению повреждений. Они являются важным компонентом иммунной системы и проявляют высокую активность на ранних стадиях воспалительных процессов.
Снижение уровня нейтрофилов может указывать на наличие инфекционного заболевания, что приводит к ослаблению защитных функций организма и усугублению симптомов недуга. Если наблюдается понижение их количества, это служит сигналом для проведения тщательного медицинского обследования, так как может свидетельствовать о наличии серьезных заболеваний.
Пониженное содержание нейтрофилов в крови у ребенка вызывает обеспокоенность у врачей, так как это может свидетельствовать о различных заболеваниях или состояниях. Специалисты отмечают, что нейтропения может быть вызвана инфекциями, аутоиммунными заболеваниями или воздействием некоторых медикаментов. Важно учитывать, что временное снижение уровня нейтрофилов может быть нормальным явлением, особенно после перенесенных вирусных инфекций. Однако, если уровень остается низким длительное время, это требует тщательного обследования. Врачи рекомендуют родителям внимательно следить за состоянием ребенка, обращая внимание на симптомы, такие как частые инфекции или усталость. Регулярные анализы крови помогут контролировать ситуацию и своевременно выявить возможные проблемы.
https://youtube.com/watch?v=_vcgpLyRJOs
Разновидности этих клеток
Нейтрофилы выделяются среди лейкоцитов своей зернистой структурой, что позволяет отнести их к группе гранулоцитов, а также характеризуется нейтральной окраской.
Нейтрофилы подразделяются на зрелые и незрелые.
Ядро зрелых нейтрофилов может иметь несколько сегментов, благодаря чему их называют сегментоядерными. В то время как молодые (или незрелые) клетки имеют форму палочки, что и дало им название палочкоядерные.
| Причина нейтропении у ребенка | Симптомы | Возможные осложнения |
|---|---|---|
| Инфекции (вирусные, бактериальные) | Лихорадка, слабость, усталость, боль в горле, кашель, насморк, диарея, рвота | Сепсис, пневмония, менингит, абсцессы |
| Аутоиммунные заболевания (системная красная волчанка, ревматоидный артрит) | Разнообразные симптомы, зависящие от пораженного органа | Повреждение органов, хроническая усталость |
| Лекарственные препараты (антибиотики, противосудорожные, химиотерапия) | Разнообразные побочные эффекты, зависящие от препарата | Угнетение костного мозга, токсичность |
| Наследственные заболевания (синдром Костмана, циклическая нейтропения) | Частые инфекции, начиная с раннего возраста | Тяжелые инфекции, сепсис |
| Дефицит витаминов и минералов (фолиевая кислота, витамин В12) | Слабость, бледность, усталость | Угнетение кроветворения, анемия |
| Апластическая анемия | Бледность, слабость, кровотечения, частые инфекции | Кровотечения, инфекции, смерть |
| Другие причины (например, злокачественные новообразования) | Разнообразные симптомы, зависящие от локализации и стадии заболевания | Метастазы, кахексия |
Допустимая норма
Нормальные показатели содержания сегментоядерных клеток в крови у детей варьируются от 15 до 70% в зависимости от их возраста.
Палочкоядерные нейтрофилы составляют 1–17% в момент рождения, однако их количество быстро снижается и через неделю достигает 1–5%.
Процесс формирования нейтрофилов является непрерывным. Их жизненный цикл довольно короткий — всего несколько дней, а иногда и часов, и зависит от наличия воспалительных процессов в организме.
Зрелые клетки перемещаются по кровеносной системе, поглощая и уничтожая бактерии, после чего погибают. Чтобы компенсировать их утрату, костный мозг постоянно производит новые клетки. Это приводит к увеличению доли молодых клеток и уменьшению старых, особенно в условиях воспалительных или инфекционных заболеваний.
Нормой считается преобладание зрелых клеток над незрелыми, что свидетельствует об отсутствии патологий. Если в крови обнаруживается более 5% палочкоядерных клеток, это может указывать на наличие серьезного заболевания.
Важно отметить, что нормы для нейтрофилов являются относительными и могут изменяться. Процентное содержание может колебаться в течение дня и зависит от эмоционального состояния, физической активности и даже от объема принятой пищи. Однако такие изменения обычно не фиксируются, так как анализы сдают в случае наличия определенных симптомов.
Тем не менее, это обстоятельство следует учитывать перед проведением лабораторного обследования, особенно если ребенок болен и необходимо определить уровень нейтрофилов как диагностический показатель. Перед сдачей анализов рекомендуется обеспечить ребенку полноценный сон, избегая шумных и активных игр перед сном. Анализы следует сдавать натощак.
Для определения уровня нейтрофилов выполняется развернутый анализ капиллярной крови, который берется из пальца.
Пониженное содержание нейтрофилов в крови у ребенка вызывает множество обсуждений среди родителей и врачей. Многие родители, столкнувшись с этой проблемой, начинают паниковать, считая, что это может указывать на серьезные заболевания. Однако важно понимать, что снижение уровня нейтрофилов, или нейтропения, может быть временным явлением и связано с различными факторами, такими как вирусные инфекции или реакция на лекарства. Врачебные рекомендации часто включают наблюдение за состоянием ребенка и повторные анализы крови. Родители делятся опытом, что в большинстве случаев нейтропения не требует интенсивного лечения, а лишь регулярного контроля. Тем не менее, важно следить за общим состоянием ребенка и при появлении симптомов, таких как частые инфекции или усталость, обращаться к специалисту.
https://youtube.com/watch?v=WCgWRE10Xso
Возрастные особенности
У детей уровень зрелых и незрелых нейтрофилов варьируется в зависимости от возраста, в отличие от взрослых, у которых эти показатели обычно стабильны.
| Возраст | Процент палочкоядерных (незрелых) нейтрофилов | Процент сегментоядерных (зрелых) нейтрофилов |
| Первый день жизни | 1–17 | 45–79 |
| В 6 месяцев | 1–3,8 | 32–65 |
| У грудных детей до года | 0,5–4 | 15–45 |
| В 1 год | 0,5–5 | 25–62 |
| В 6 лет | 1,5–4,3 | 30–51 |
| С 13 до 15 лет | 0,5–6 | 40–65 |
| С 16 лет и старше | 1–6 | 47–72 |
Обратите внимание! Данная таблица не предназначена для самостоятельного лечения, она лишь помогает понять изменения, происходящие в организме ребенка. Назначение курса лечения должно осуществляться квалифицированным специалистом.
О чем говорит изменение в показателях
Сдвиг уровня нейтрофилов в крови как в большую, так и в меньшую сторону может представлять серьезную угрозу для здоровья ребенка.
Если количество нейтрофилов превышает норму, это может свидетельствовать о наличии таких заболеваний, как болезни печени и почек, бронхит, аппендицит или сахарный диабет. Также изменения в их количестве могут указывать на онкологические заболевания.
Снижение уровня нейтрофилов у ребенка может говорить о следующих проблемах:
- уменьшении их выработки костным мозгом;
- повышенной разрушительности клеток;
- наличии серьезных заболеваний;
- снижении иммунной защиты из-за тяжелых заболеваний.
К числу болезней, способных вызвать снижение нейтрофилов, относятся грибковые инфекции, корь, краснуха и инфекционный гепатит. В редких случаях низкий уровень нейтрофилов может быть связан с наследственными факторами.
https://youtube.com/watch?v=_wDa3bySanw
Факторы, способные спровоцировать понижение нейтрофилов
Низкий уровень нейтрофилов в крови у ребенка может быть вызван множеством причин, среди которых наиболее важными являются:
- тяжелые вирусные инфекции;
- хронические бактериальные инфекции, такие как эндокардит;
- грибковые инфекции;
- вирусный гепатит;
- туберкулез;
- ослабленный иммунный ответ;
- использование антибиотиков и противовоспалительных средств;
- ВИЧ-инфекция;
- нарушения в процессе кроветворения;
- наследственные предрасположенности;
- онкологические заболевания.
Не менее важным аспектом низкого уровня нейтрофилов является изменение соотношения молодых и зрелых клеток, что может проявляться как их уменьшением, так и увеличением. Обычно снижение количества зрелых клеток связано с чрезмерной продукцией незрелых клеток костным мозгом.
Это может происходить в условиях тяжелых воспалительных процессов или при онкологических заболеваниях, так как палочкоядерные нейтрофилы более чувствительны к таким состояниям, чем сегментоядерные.
Существенное снижение уровня нейтрофилов является тревожным сигналом о серьезных нарушениях в организме и требует немедленного и более детального обследования всех систем для предотвращения их дальнейшего прогрессирования.
Симптомы
Состояние, при котором у ребенка или взрослого наблюдается снижение уровня нейтрофилов, называется «нейтропения». Клинические проявления этого состояния могут проявляться через гнойную ангину, стоматит, цистит, а также бессимптомные воспалительные процессы, которые могут привести к остеомиелиту.
Симптоматика нейтропении варьируется в зависимости от ее причин. В некоторых случаях могут наблюдаться достаточно простые, на первый взгляд, признаки:
- общая слабость;
- повышенная утомляемость;
- усиленное потоотделение;
- предрасположенность к частым простудам.
Более серьезные симптомы, указывающие на снижение уровня нейтрофилов, включают стоматит, пародонтоз и множество воспалительных образований на коже в виде гнойничков.
В сложных случаях может наблюдаться повышение температуры и лихорадка.
Бессимптомное течение нейтропении у младенцев не считается патологией, так как к трем годам уровень нейтрофилов обычно приходит в норму.
Лечение
При подтверждении снижения уровня нейтрофилов необходимо провести детальное лабораторное и инструментальное обследование всех систем организма. Это поможет выявить причины, вызвавшие патологические изменения. Только после этого врач сможет назначить соответствующее лечение, направленное на восстановление уровня нейтрофилов.
Важно отметить, что терапия всегда ориентирована на устранение факторов, ставших причиной нейтропении. При правильно подобранном лечении, основанном на выявленных причинах, восстановление показателей не представляет сложности. Например, после перенесенных инфекций уровень нейтрофилов может восстановиться самостоятельно.
Ключевым аспектом в лечении нейтропении является укрепление иммунной системы ребенка. Для этого рекомендуется пройти курс витаминов, улучшить рацион питания и временно ограничить физическую активность.
Если наблюдаются симптомы стоматита или гингивита, врач может порекомендовать регулярные полоскания отварами трав с антисептическими свойствами, такими как зверобой или ромашка. Также хорошо зарекомендовал себя препарат Ротокан.
В некоторых случаях может быть назначено медикаментозное лечение. Это актуально при прогрессирующей нейтропении. Использование таких препаратов, как Метилурацил и Пентоксил, требует консультации иммунолога и проведения иммунограммы.
При стойком снижении уровня нейтрофилов возможно применение Филграстима и Ленограстима. Эти мощные препараты имеют множество побочных эффектов, поэтому их назначение допустимо только в стационарных условиях под наблюдением квалифицированных специалистов.
Своевременное выявление первичных заболеваний является важным элементом успешного лечения, что позволяет предотвратить ряд серьезных осложнений для здоровья.
Основным профилактическим мероприятием является поддержание детского организма в естественном здоровом состоянии, что способствует его способности противостоять различным инфекциям, которые нейтрофилы могут нейтрализовать.
Информация о лечении представлена исключительно для ознакомления и не предназначена для самостоятельного применения. Попытки самостоятельно справиться с заболеванием могут привести к его тяжелой форме.
Вопрос-ответ
О чем говорит пониженное содержание нейтрофилов?
Нейтропения – это снижение числа нейтрофилов в крови. Выраженная нейтропения приводит к повышению риска и тяжести бактериальной и грибковой инфекции. Местные симптомы инфекции могут быть ослаблены, но в большинстве случаев серьезные инфекции сопровождаются лихорадкой.
Что может означать небольшое понижение нейтрофилов?
Повышенное количество нейтрофилов часто может быть свидетельством воспалительного процесса самого различного генезиса. Наблюдается при острых бактериальных инфекциях, заболеваниях печени и почек. Пониженное содержание нейтрофилов часто наблюдается при вирусных заболеваниях (например, грипп, гепатит, краснуха и т. д.).
Советы
СОВЕТ №1
Обратитесь к врачу для детального обследования. Пониженное содержание нейтрофилов может быть признаком различных заболеваний, поэтому важно провести полное медицинское обследование, чтобы выявить возможные причины и назначить соответствующее лечение.
СОВЕТ №2
Следите за общим состоянием ребенка. Обратите внимание на симптомы, такие как частые инфекции, усталость или слабость. Если вы заметили изменения в поведении или здоровье ребенка, обязательно сообщите об этом врачу.
СОВЕТ №3
Обеспечьте ребенку сбалансированное питание. Включите в рацион продукты, богатые витаминами и минералами, особенно витамином C и цинком, которые поддерживают иммунную систему. Это может помочь улучшить общее состояние здоровья и повысить уровень нейтрофилов.
СОВЕТ №4
Регулярно проводите профилактические осмотры. Посещение педиатра и выполнение необходимых анализов помогут контролировать уровень нейтрофилов и общее состояние здоровья ребенка, а также своевременно выявлять возможные проблемы.